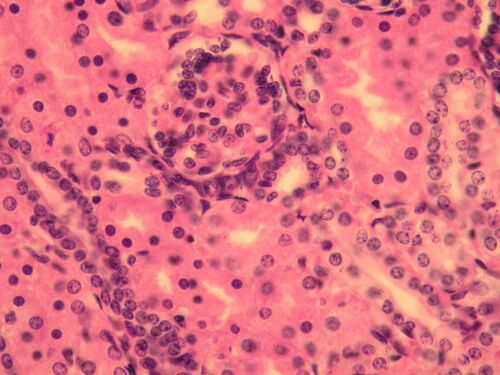
Kidney cortex.jpg

Kidney (preparate)
Kidney B2[edit | edit source]
Overview[edit | edit source]
Preparation 1[edit | edit source]
Name: Kidney stained with hematoxylin eosin (HE)
Description:
The cortex of the kidney contains renal bodies (corpusculum renale). The renal corpuscle consists of a glomerulus of blood capillaries and Bowman's capsule. The parietal sheet of Bowman's capsule is made up of one-layer flat epithelium. The nuclei of the epithelial cells are flattened, the cytoplasm is almost invisible. Inside Bowman's capsule there is a glomerulus (a ball of blood capillaries), which is covered by the visceral sheet of Bowman's capsule, which is made up ofpodocytes. In the vicinity of the renal corpuscle (glomerulus + Bowman's pouch) we see proximal and distal canals.
1 – proximal tubules (note the large, eosinophilic cells)
2 – distal tubule (cubic epithelium, round nuclei fill most of the cytoplasm)
3 – kidney body
4 – vessel
Preparation 2[edit | edit source]
Name: Renal cortex (HE)
Description:
1 – kidney bodies (glomerulus and Bowmann's capsule)
2 – proximal tubules (larger and more eosinophilic)
3 – distal tubules
4 – fibrous capsule of the kidney
Preparation 3[edit | edit source]
Name: Kidney cortex (HE)
Description: In addition to the renal corpuscle (Bowman's capsule and glomerulus), there are proximal tubules (eosinophilic - pink) with fewer nuclei and obscured lumina. These cells participate in resorption (they have a brush border on the apical surface, mitochondria and folds of cytoplasm with Na/K-ATPase at the base). Distal canals are smaller and have a free lumen. They only resorb water and ions, therefore they only have a baso-lateral labyrinth. In the distal duct near the glomerulus, cells specialize in detecting the composition of urine (macula densa). They are taller with oval cores.
Preparation 4[edit | edit source]
Name: Renal Medulla (HE)
Description: In the medulla we see collecting ducts (higher light epithelium) and thin segments of the loop of Henle (flat epithelium).
Preparation 5[edit | edit source]
Name: Kidney (HE)
Description: A view of the arrangement of the kidney cortex. Renal bodies are stacked on top of each other (gradual development of new generations of nephrons). This area is referred to as the columnae renales. The striae medullares (collecting ducts that connect to the nephrons) run into the cortex.
Preparation 6[edit | edit source]
Name: Kidney (HE)
Description: Kidney at low magnification. The basic structural unit of the kidney is the nephron = renal corpuscle, proximal tubule, thin segment of the loop of Henle, distal tubule. The arrow points to the renal corpuscle.